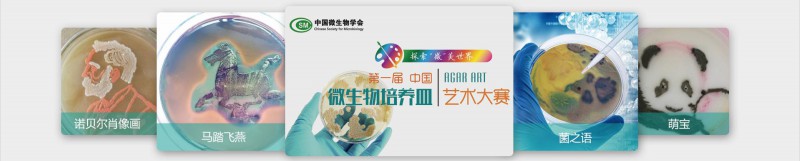
琼脂匠心，传播科研艺术之美

专家寄语
“制作微生物培养皿是生物科研工作者的基本功,没想到基琼脂匠心,传播科研艺术之美本功练扎实了也能创作出这么多美轮美奂的艺术佳作,现在国家弘扬工匠精神,培养皿艺术大赛正和彰显工匠精神不谋而合,希望培养皿艺术大赛越办越好,有更多的科研工作者参与。”
上下五千年,无数能工巧匠用智慧和精湛技艺塑造了我们辉煌的华夏文明;现代科技时代,实现中华民族伟大复兴的中国梦,更需要朴素的“工匠精神”。
由中国微生物学会主办、安琪酵母股份有限公司承办的“第一届中国微生物培养皿艺术大赛”自去年创办以来,共收到202家单位的231位参赛者共计359份参赛作品,数十万人次的投票,在生物科研领域掀起了培养皿艺术创作的热潮。

举办微生物培养皿艺术大赛的初衷是为了向大众展示多姿多彩的微生物世界,同时为微生物科研工作者增添工作乐趣。
2018年,我们迎来了“第二届中国微生物培养皿艺术大赛”,让培养皿这项微生物工作者熟悉的基本技术,成为承载“工匠精神”与艺术创作的最佳载体,展现“琼脂匠心,传播科研艺术之美”的大美意境。
快来参与吧,让我们用一双巧手,在培养皿的方寸之地展现敬业、精益、专注、创新的“工匠精神”,在柔嫩的琼脂上描绘出绚烂的匠心之花,用微生物之美记录我们璀璨的芳华。

大赛名称:第二届中国微生物培养皿艺术大赛
主办单位:中国微生物学会
承办单位:安琪酵母股份有限公司


参赛要求:
1、微生物以及琼脂平板培养基类型不限,通过微生物培养来创作艺术图形,不得直接使用画笔与颜料描绘;
2、参赛者应保证作品的首创性和可复制性,无著作权争议,不得对上传作品的图形和颜色进行后期修饰,为作品的美感,可以进行亮度、对比度、清晰度调节;
3、上传作品须按示例作品样式,保证作品图形的清晰可见,图片尺寸不低于1024*768px,分辨率72dpi,格式为JPG;
4、每位参赛者只能提交1幅作品,每幅作品只能在一个培养皿中完成(培养皿尺寸与形制不限);
5、上传作品时需提交作者姓名、联系电话、作品名称、创意描述、制作材料以及制作过程(以备可复制性验证);作品图片上不得留有作者个人相关信息。
6、为证明作品的原创性,请将注册ID用户名和作品名称、日期标注于培养皿盖子上,与作品一起展示,作为原创性证明拍摄上传;
7、本次大赛不收参赛费,所有入选及参赛作品恕不退还;
8、获奖作品参赛者承诺,允许主办与承办单位将获奖作品用于以宣传、展览、出版画册及媒体等用途,不再另付稿酬,作者享有署名权。
9、参赛作品涉及著作权、肖像权、署名权、名誉纠纷等法律责任由作者负责,举办单位不负任何连带责任。参赛作品如发现剽窃、侵权或第三方提出权利主张的,大赛主办方有权随时撤销该作品的参赛权,收回已获得的奖励和荣誉,并在相关媒体予以通报。
10、带宣传效果的作品,如企业商标、logo、名称、二维码的作品不得参赛;有违反国家法律法规、违背公序良俗的作品不得参赛。
*本次活动的解释权归属于大赛组委会,参加本次大赛即视为同意并遵守本次大赛各项规则。*
大赛组委会联系电话: 0717-6787989
联系人:姜萌18695076804


